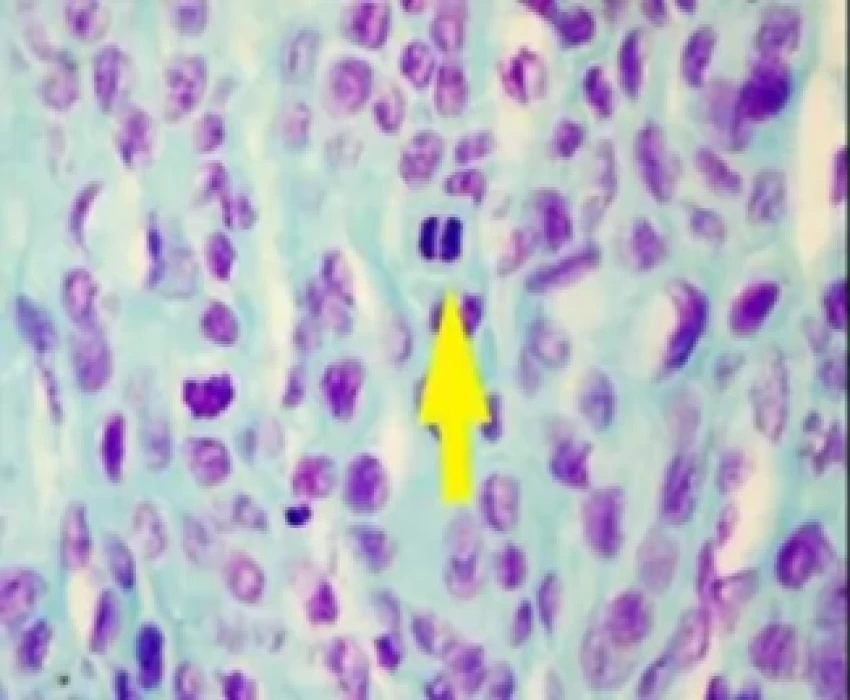
saraswati dental college

Oral Squamous Cell Carcinoma
Human body is the result of mitotic proliferation in accordance with cellular diversification. Mitosis remains restricted to somatic stem cells that eventually repair injuries, and to committed stem cells that substitute for tissue turnover. It is a highly dynamic process and the various stages include Prophase, Prometaphase, Metaphase, Anaphase, and Telophase. The various chromosomal arrangement in mitotic cells are referred to as mitotic figures which can be appreciated in tissue sections as different phases of mitosis.
Nuclear abnormalities like pyknotic nuclei, broke egg appearance, binucleation, micronuclei, and increased number of normal and abnormal mitotic figures are caused by variable genetic alterations owing to any defect during the process of mitosis. Excessive proliferation of cells due to increased mitosis is the hallmark in oral precancer and cancer.
Literature search has unveiled that selective stains like Crystal violet, Toluidine blue, Feulgen, and Giemsa can highlight the chromatin pattern and therefore are used to stain mitotic figures in oral tissues as well as in brain tissue, uterus, and in breast carcinoma.
Haematoxylin and Eosin (H.E) has been used for more than 130 years and is the most popular histological staining method used in routine microscopy and histopathology. The H.E is an effective stain for demonstrating major histological structures, particularly nuclei which are the most important structures in viewing histological sections for pathological changes. Hence this study was carried out to find a better alternative staining technique in the identification of mitotic figures as the number of mitotic figures seen in the tissue sections is an important factor in grading malignancies and also in the determination of prognosis with an aim to compare and evaluate the efficacy of Haematoxylin and Eosin, Crystal Violet Toluidine Blue, Feulgen and Giemsa stains in identification of Mitotic Figures in Oral Squamous Cell Carcinoma (OSCC).